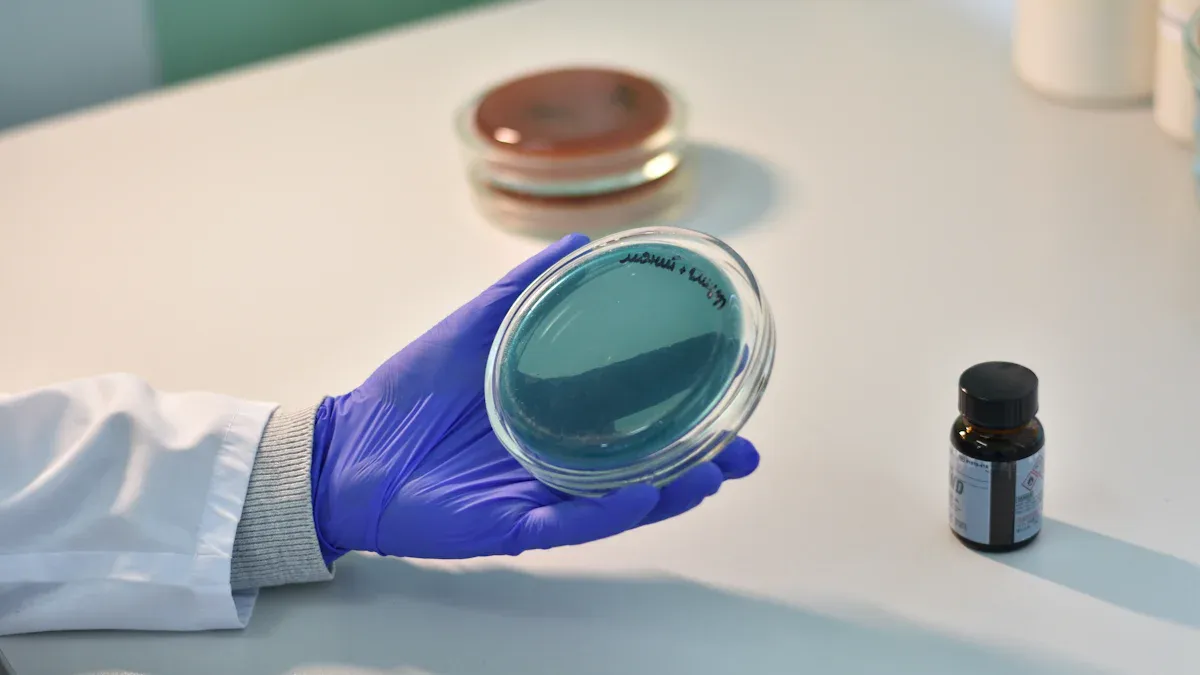
Superior Strength and Safety

For most modern projects, you should choose acrylic instead of glass. Modern acrylic is significantly stronger and lighter than traditional glass, offering clear advantages. The safety difference is a major factor.
Did You Know? Each year, U.S. emergency rooms treat approximately 20,000 children for injuries related to glass doors and windows.
Exploring the benefits of using acrylic reveals why this material provides greater peace of mind. This shift away from glass makes projects safer and more manageable.
Superior Strength and Safety
When you compare materials, strength and safety are top priorities. The choice between acrylic and glass becomes very clear in this area. Acrylic offers a level of durability that traditional glass simply cannot match.
Why Choose Acrylic Over Glass
You should choose acrylic over glass for its incredible impact resistance. Modern acrylic is up to 17 times stronger than a glass panel of the same thickness. This strength makes it a reliable material for almost any project. The difference in impact strength is significant.
Impact Strength Comparison The Izod Impact test measures how well a material resists a sudden blow. A higher number means greater strength.
Material Izod Impact Strength (J/m) Acrylic 15-25 Standard Annealed Glass < 1
This data shows why acrylic is the smarter choice for durability.
Shatterproof vs. Fragile
The biggest safety advantage of acrylic is how it behaves under stress. Glass is fragile. When it breaks, it shatters into countless sharp, dangerous shards. These pieces can cause serious injuries.
Acrylic, on the other hand, is shatter-resistant. If it experiences an impact beyond its limit, it is more likely to crack. If it does break, it fractures into large, dull-edged pieces. This quality makes handling a broken panel much safer and cleanup far easier. You eliminate the risk of hazardous splinters that you get with broken glass.
Enhanced Home and Public Safety
Using acrylic instead of glass makes spaces safer for everyone. In your home, you can use acrylic for tabletops, shelving, and cabinet doors. This is especially important in homes with children or pets, as it removes the danger of shattered glass. Many parents use acrylic for room dividers and protective barriers around stairways.
Public venues also rely on acrylic for safety. You see it in:
- Sports Arenas: Hockey rinks use clear acrylic panels to protect fans from flying pucks without blocking the view.
- Aquariums and Zoos: Massive acrylic windows give you breathtaking underwater views of marine life, safely holding back millions of gallons of water.
- Retail and Public Buildings: Protective barriers and display cases made from acrylic meet strict safety standards, including fire resistance ratings like
UL94 V-0.
These applications are possible because impact-modified acrylic meets building codes for high-traffic areas, ensuring public safety.
Better Thermal Insulation
Acrylic provides benefits beyond just impact strength. It is a better insulator than glass. This means it helps keep heat inside during the winter and outside during the summer. This improved insulation leads to better draft reduction in your home. Over time, this can help lower your energy bills.
Acrylic also offers superior noise reduction. It is more effective at blocking sound waves than glass of the same thickness. This quality helps you reduce noise from outside, creating a quieter and more peaceful indoor environment. The excellent noise reduction makes it a great choice for windows or partitions facing busy streets.
Lightweight and Easy Handling
The physical weight of a material dramatically impacts your project from start to finish. Handling heavy materials is difficult, expensive, and risky. This is where the benefits of using acrylic instead of glass become incredibly practical. The lightweight nature of acrylic makes every step of the process simpler and more efficient.
Using Acrylic Instead of Glass
When you choose a material for your project, you must consider its weight. A heavy material requires more support, more labor, and more caution. Acrylic offers a significant advantage here. It is a lightweight yet robust material that simplifies handling and installation. You can move and position acrylic panels with far less effort compared to traditional glass.
A Difference You Can Feel A sheet of acrylic weighs less than half of a glass sheet of the exact same size and thickness. This massive weight reduction changes everything about how you work with the material.
Half the Weight, Easier Install
The lighter weight of acrylic makes installation much faster and safer. You can carry larger panels more easily, and you often need fewer people for the job. This is a huge benefit for large-scale applications like patio roofs or sliding doors. For architectural projects, the reduced weight of acrylic lessens the load on the building’s support structure. This can even lower construction costs because you may not need extra structural reinforcement.
Installing an acrylic shower door, for example, is much more manageable than wrestling with a heavy glass one. You can see how this impacts installation time.
| Door Material | Average Installation Time |
|---|---|
| Acrylic | 1-2 hours |
| Standard Glass | 2-4 hours |
This time savings comes from easier handling and positioning, making your project move along more quickly.
Lower Shipping and Labor Costs
Your project’s budget will thank you for choosing acrylic. Since it weighs so much less than glass, shipping costs are significantly lower. Carriers base their fees on weight, so cutting the weight in half leads to direct savings.
Labor costs also decrease. A heavy glass panel might require two or three installers for safety. A comparable acrylic panel often needs only one person. This reduces the number of workers you need to hire and pay. The reduced risk of breakage during transport and installation also prevents costly replacement orders, keeping your project on budget.
Ideal for DIY Projects
Are you planning a do-it-yourself project? Acrylic is your best friend. Its light weight and forgiving nature make it perfect for home creators. You can confidently tackle projects that would be too dangerous or difficult with glass.
Popular DIY projects made easier with acrylic include:
- Custom Aquariums: Building a fish tank is simpler because the acrylic panels are easy to move and bond together.
- Tabletop Protectors: You can cut a sheet of acrylic to size yourself to protect a dining table or desk.
- Picture Frames: Create custom, shatterproof frames without the fear of dropping and breaking heavy glass.
- Small Greenhouses: Construct a small greenhouse in your backyard with panels you can easily lift and fasten.
You can cut, drill, and shape acrylic using common workshop tools like a table saw with a fine-tooth blade and standard drill bits. You can fasten panels with screws, double-sided tape, or even magnetic tape for easy removal. This accessibility empowers you to bring your creative ideas to life safely and effectively.
Optical Clarity and Customization

Your project’s appearance is just as important as its strength. You might think glass is the only option for a crystal-clear view, but modern acrylic offers superior optical quality and unmatched design freedom. This makes using acrylic instead of glass a smart choice for visual projects.
Unmatched Light Transmission
Many people believe glass is clearer than acrylic, but this is a common myth. High-quality acrylic actually allows more light to pass through. It has a light transmission rate of over 90%, which is comparable to expensive low-iron glass. This gives you exceptional high clarity without the extra cost.
Did you know? High-quality acrylic contains UV stabilizers. These additives prevent the material from turning yellow over time, even when used outdoors. Your projects will maintain their clearness for decades, a feature that lower-quality plastics and even some types of glass cannot guarantee.
Superior Design Flexibility
You can shape acrylic into almost any form you can imagine. Unlike glass, which has limits on how much you can bend it, acrylic is incredibly versatile. You can create smooth curves and unique designs without losing optical quality. This flexibility opens up a world of creative possibilities for furniture, displays, and architectural features.
Easy to Cut, Drill, and Shape
Working with acrylic is simple and safe, making it perfect for your projects. You can cut, drill, and shape it with common workshop tools. When you need to drill a hole, you can avoid cracks by following a few easy steps:
- Use a drill bit designed for plastic.
- Secure the acrylic sheet so it does not move.
- Apply gentle, steady pressure while drilling.
- Pause occasionally to clear away debris.
This ease of fabrication gives you the power to customize your projects at home.
Wide Range of Colors and Finishes
Your design choices are nearly endless with acrylic. It comes in a huge variety of colors and finishes that you cannot find with standard glass. You can choose from options like:
- Frosted or matte finishes for privacy
- Mirrored sheets in standard or colored tints
- Vibrant fluorescent and pearlescent colors
- Opaque, translucent, and transparent color options
This wide selection allows you to perfectly match your project to your creative vision.
Choosing acrylic instead of glass is the smart decision for 2025. Your projects benefit from acrylic’s superior strength, safety, and light weight. This translates to lower long-term costs and greater peace of mind, as you can easily repair minor damage on acrylic surfaces. While glass offers high scratch resistance for very specific needs, the unmatched design flexibility of acrylic makes it the superior material for most applications. You get a durable, safe, and cost-effective result with glass.
FAQ
Is acrylic more expensive than glass?
Initially, an acrylic sheet may cost more than a standard glass panel. You save money on shipping and installation due to its light weight. Its durability also prevents costly replacements, making it a smart long-term investment.
Does acrylic scratch easily?
Standard acrylic can scratch more easily than glass. You can easily buff out minor scratches yourself. For high-traffic areas, you can choose special coated acrylics that offer enhanced scratch resistance and durability.
Can I use acrylic for a window replacement?
Yes, acrylic is an excellent choice for a window replacement. It offers better insulation and superior noise reduction compared to a standard glass window. This improved noise reduction creates a quieter home for you.
How does acrylic help with noise reduction?
Acrylic is denser than glass. This density helps it block sound waves more effectively. This property provides excellent noise reduction from outside disturbances like traffic, making your indoor space much more peaceful.
See Also
Simplifying Your Decision: Glass or Acrylic Coffee Tables Explained
Understanding Impact-Modified Acrylic: Its Properties, Uses, and Benefits
Acrylic Aquariums: Exploring Their Definition, Characteristics, and Practical Uses
Discovering Acrylic Blocks: Understanding Their Nature, Traits, and Functions
Distinguishing Features: Why Acrylic and Glass Coffee Tables Shine


